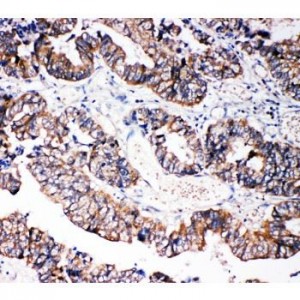
Caspase-3(P10)

Immunohistochemistry (IHC)
Showing 901–912 of 1068 resultsSorted by latest
-

Caspase-3(P17) Antibody
$330.00 Add to cart -

Caspase-3(P10) Antibody
$330.00 Add to cart -
Caspase-3(P10)
$330.00 Add to cart -

Caspase-3 Antibody
$365.00 Add to cart -

Caspase-14 Antibody
$330.00 Add to cart -

Caspase-12 Antibody
$330.00 Add to cart -

Caspase-10 Antibody
$330.00 Add to cart -

Caspase-1(P20) Antibody
$330.00 Add to cart -

Caspase-1(P10) Antibody
$330.00 Add to cart -

Caspase 9 Antibody
$330.00 Add to cart -

Caspase 4 Antibody
$330.00 Add to cart -

cardiac Troponin C Antibody
$330.00 Add to cart